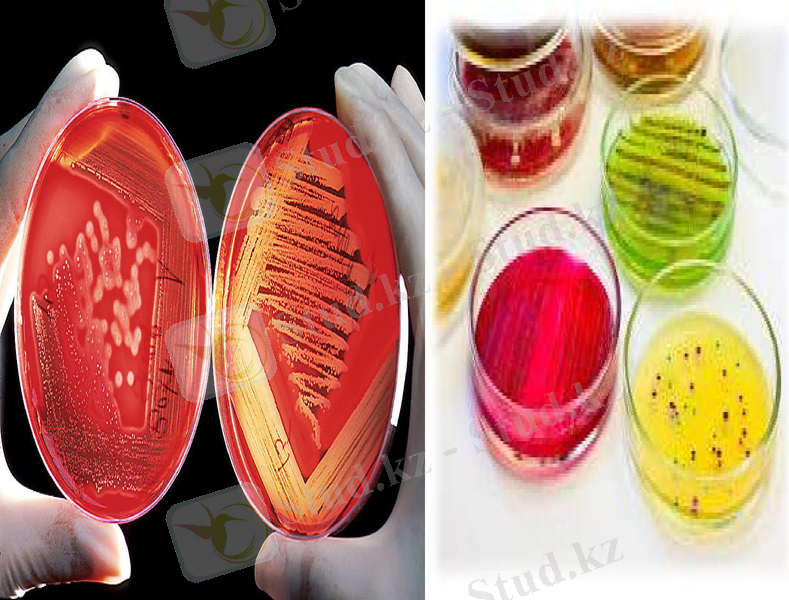
Slide 20

Микроорганизмдерді өсіруде қолданылатын зертханалық құрал-жабдықтар



Микроорганизмдерді өсіруде қолданылатын құрал-жабдықтар
Орындаған:
Тобы: Қабылдаған:

(әр түрлі бояуларға, бояу әдістеріне қатынасы), құрылымын (ұрық, капсула), жылжымалығын зерттеуге арналған құрал. Микроскоптың жәрдемімен мироорганизмдерді ашқан (1673 - 77) голланд ғалымы А. Левенгук.
Микроскоп (грек. mіkros - ұсақ және грек. skopeo - көремін) - жай көзге көрінбейтін нысандардың(немесе олардың құрылымдық бөліктерінің) бірнеше есе үлкейтілген кескінін алатын оптикалық прибор. Микроскопия микроорганизмдердің морфология
лық ерекшеліктерін, тинкториалдық қасиеттерін
Микроскоп



Автоклав - автоклавтың жұмыс істеу механизімі - жоғарғы қысымдағы бу арқылы материалдарды (шыны заттары, резина, пластамасса, мақта және дәке тампондары, халат, маска т. б. ) стерильдеуге негізделген.
Автоклав


Колбалар - шар және конус тәрізді болып келеді. Сыйымдылықтары 50 мл - 10 литрге дейінгі аралықта болады. Кең және тар мойынды, қақпақты және қақпақсыз түрлері кездеседі. Конус тәрізді колбаларды «Эрленмейер» колбасы деп атайды. Олар микроорганизмдерді өсіруде қолданылады.
Колбалар



Микробиологиялық шпатель - үшбұрышты ашық ілмекті қалыптастыратын қисық шыны панель. «Шпатель» атауы микробиологиялық шпатканы микробиологиялық циклден ажырату үшін пайдаланылады.
Микробиологиялық шпатель

Микробиологиялық тұзақ - нихром сымынан бұралған микро биологиялық цикл, микроорганизмдердің тығыз немесе сұйық қоректік орталарынан манипуляцияларға егу үшін арналған. Ілмек ұзындығы 60-дан 70 мм-ге дейінгі бұрылыс шыбықтан және 1, 2, 3, 4, 5 мм ішкі диаметрі бар сақинадан тұрады.
Микробиологиялық тұзақ


Термостат-бұл қондырғы микроорганизмдерді бір қалыпты температурада өсіруге тағайындалған. Микроорганизмдердің негізгі оптимальды көбею температурасы 37оС.
Термостат


Микроанаэростат - микроорганизмдерді
анаэробты жағдайда өсіретін аппарат. Яғни оттегіні қажет етпейтін микроорганизмдерге арналған болып табылады.
Микроанаэростат

Пробиркалар - бұл ыдыстың ішіндегі ең көбірек қолданылатыны әр түрлі пішінді, әртүрлі материалдан дайындалған ыдысты айтады. Олар цилиндр тәрізді, түбі доғалданған, әртүрлі көлемді, әртүрлі шынылардан дайындалған түтіктер. Лабораториялық пробиркаларды жеңіл балқитын шынылардан дайындайды. Бірақта жоғары температурада қолданылатын пробиркаларды қиын балқитын немесе кварцтан дайындайды.
Пробиркалар



Петри табақшасы-аласа әрі жалпақ келген цилиндрлі, әйнек не пластмассадан жасалған, қақпағы бар ыдыс. Петри табақшасы бактериологиялық зертханада қатты қоректік ортада бактерияларды өсіру үшін қолданылады. 1887жылы неміс ғалымы Петри ұсынған. Петри табақшасы екі табақшадан тұрады, оның диаметрі үлкен қақпағы болып саналады.
Петри табақшасы

Центрифуга - микроорганизмдерді біртекті емес сұйықтықтардан бөліп алу үшін қолданылады. Центрифуганың негізгі бөлігі ротор болып саналады. Ол роторда тесіктер болады да, оған сұйығы бар пробиркалар орналастырылады.
Центрифуга


Пипеткалар - сұйықтың белгілі бір дәл мөлшерін анықтау үшін қолданылады. Олар сұйықтың және газдың мөлшерін анықтайтын пипеткалар болып бөлінеді. Кәдімгі пипеткалар - ортасында кеңейтілген жері бар, диаметрі онша үлкен емес шыны түтікше. Оның төмен ұшы сүйірленген, диаметрі 1 мм - ге жуық. Сыйымдылығы 1 - 10 мл болатын, шлифті тығынды немесе тығынсыз автоматты пипеткалар да қолданылады. Оларды әрбір 0, 01мл-ге тең бөліктерге бөліп белгілейді.
Пипеткалар



Ламинарлы бокс - бұл стерильді жағдайларда биологиялық объектілермен жұмыс істеу үшін зертханалық құрылғы. Бұл жарықтандырғыштар, ультракүлгін лампалар және стерильді ауа беру жүйесі бар шкаф. Стерильді ауа ламинарлы ағынмен қоректендіріледі. Бокстың жылжымалы
есігі бартамбуры болады. Бокстың терезесі сыртқы ортадан ауа кірмейтіндей әйнектеліп, қабырғалары плиткаменқапталады немесе майлы бояумен сырланады. Еденіне линолеум төселеді. Боксты
натрий гидрокарбонатын(ас содасын 2-3%-ы), 3-5%ды карбол қышқылы және басқа да дезинфек
циялағыш заттардың ерітінділерімен
ылғалдандырып, жуып тұрады.
Ламинарлы бокс


Назарларыңызға рахмет!
- Іс жүргізу
- Автоматтандыру, Техника
- Алғашқы әскери дайындық
- Астрономия
- Ауыл шаруашылығы
- Банк ісі
- Бизнесті бағалау
- Биология
- Бухгалтерлік іс
- Валеология
- Ветеринария
- География
- Геология, Геофизика, Геодезия
- Дін
- Ет, сүт, шарап өнімдері
- Жалпы тарих
- Жер кадастрі, Жылжымайтын мүлік
- Журналистика
- Информатика
- Кеден ісі
- Маркетинг
- Математика, Геометрия
- Медицина
- Мемлекеттік басқару
- Менеджмент
- Мұнай, Газ
- Мұрағат ісі
- Мәдениеттану
- ОБЖ (Основы безопасности жизнедеятельности)
- Педагогика
- Полиграфия
- Психология
- Салық
- Саясаттану
- Сақтандыру
- Сертификаттау, стандарттау
- Социология, Демография
- Спорт
- Статистика
- Тілтану, Филология
- Тарихи тұлғалар
- Тау-кен ісі
- Транспорт
- Туризм
- Физика
- Философия
- Халықаралық қатынастар
- Химия
- Экология, Қоршаған ортаны қорғау
- Экономика
- Экономикалық география
- Электротехника
- Қазақстан тарихы
- Қаржы
- Құрылыс
- Құқық, Криминалистика
- Әдебиет
- Өнер, музыка
- Өнеркәсіп, Өндіріс
Қазақ тілінде жазылған рефераттар, курстық жұмыстар, дипломдық жұмыстар бойынша біздің қор #1 болып табылады.



Ақпарат
Қосымша
Email: info@stud.kz